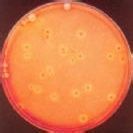
非結合膽紅素

名稱
非結合膽紅素(UCB診斷學)
正常範圍
小於11.1微摩/升(<0.65毫克/分升)。
檢查介紹
總膽紅素(TCB)是由非結合膽紅素(UCB)和結合膽紅素(CB)組成,非結合膽紅素即不與葡萄糖醛酸結合的膽紅素。
臨床意義
增高
見於嚴重燙傷、敗血症、瘧疾、血型不合輸血、脾功能亢進、惡性貧血、珠蛋白生成障礙性貧血、鉛中毒、新生兒生理性黃疸、藥物性黃疸、體質性黃疸、哺乳性黃疸等
總膽紅素和非結合膽紅素增高,為溶血性黃疸
總膽紅素和結合與非結合膽紅素均增高,為肝細胞性黃疸;結合膽紅素與總膽紅素的比值,>35%為阻塞性或肝細胞性黃疸;比值<20%為溶血性黃疸。
偏高原因
肝臟疾患
一些惡性疾病也會導致血中的非結合膽紅素偏高。如急性黃疸型肝炎、急性黃色肝壞死、慢性活動性肝炎、肝硬化等。
溶血性貧血
肝人體內紅細胞大量破壞,釋放出非結合膽紅素,當血中非結合膽紅素過多時,超過了肝臟的轉化能力,使非結合膽紅素在血中滯留,從而起血中非結合膽紅素偏高,這種情況也被稱之為溶血性黃疸,患者通常會有皮膚發黃、鞏膜發黃、尿色發黃症狀。
血型不合輸血
4、肝細胞性黃疸 當輸入血型不合的血液,會導致溶血,使體內紅細胞大量破壞,從而導致血液中的非結合膽紅素偏高。
當肝細胞發生病變時,或者因膽紅素不能正常地轉化成膽汁,或者因肝細胞腫脹,使肝內的膽管受壓,排泄膽汁受阻,使血中的膽紅素升高。
新生兒黃疸
當新生兒出生以後,48-72小時出現黃疸(並不按照面部、頂部、軀幹、四肢的順序出現黃疸),精神不好,且2周內沒有消退,這主要是因此母子血型或者新生兒先天性膽道畸形等起的,這種情況也會導致血液中的非結合膽紅素偏高。
偏高對策
起非結合膽紅素偏高的原因有很多,建議到醫院做一個詳細的檢查,查明是由什麼原因起的非結合膽紅素升高,然後採取針對性治療。如果是B肝患者非結合膽紅素偏高,此時建議檢查肝功能其它指標和B超檢查,預防肝硬化的發生。如果肝功能其他各項指標正常,也不要放鬆警惕,要注意定期複查。非結合膽紅素偏高者,在日常生活中要避免酗酒、長期熬夜等不良的生活習慣。如果發現非結合膽紅素偏高,不要盲目用藥,一定要在醫生的指導下選擇使用藥物。
偏高風險
關於非結合膽紅素偏高的風險,大部門人知之甚少,專業人士總結了三點風險供各人參考:
一.如果紅細胞破壞過多,孕育發生的非結合膽紅素過多,肝臟不克不及純粹把它轉化為結合膽紅素,可以發生溶血性黃疸。
二.當肝細胞發害病變時,或因膽紅素不克不及正常地轉化成膽汁,或因肝細胞腫脹,使肝內的膽管受壓,分泌膽汁受阻,使血中的膽紅素升高,這時就發生了肝細胞性黃疸;一旦肝外的膽道系統發生腫瘤或呈現結核,將膽道阻塞,膽汁不克不及順利分泌,而發生阻塞性黃疸。
三.膽紅素是血液中紅血球的猩紅素代謝後的燒毀物。任何一個環節呈現停滯,都可使人發生黃疸。但若是血清中膽紅素過高時,卻吐露出肝臟病變或膽管阻塞等異樣訊息,血清膽紅素的數值的高低代表著異樣的嚴重程度。